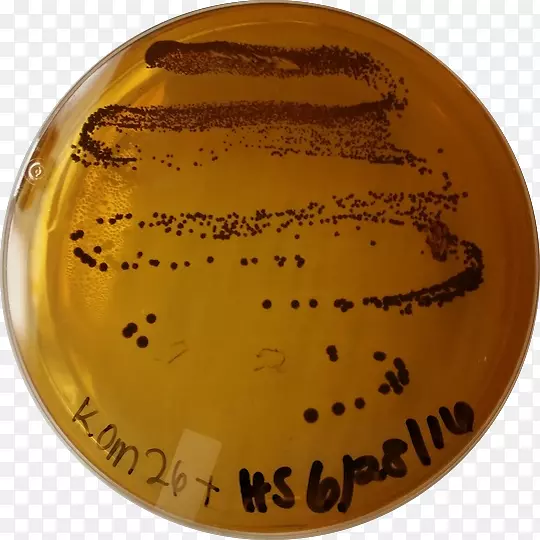
�¿���˹��ѧ��˹͡��У������ݷ�����ѧ���ʻ��򹤳̻�����-������

黑白摄影艺术作品作者-弗伦泽的卡斯塔・达斯特古利奥(curio Casa d‘Aste in Firenze)

马克斯・罗卡特斯基王子勇敢的YouTube普利茅斯勇敢的疯狂的麦克斯-YouTube

塞里斯安全比利时大拇指击剑通信

史密斯奶奶苹果奥格利斯手绘蓝色苹果

有机体-奥利奥冰淇淋

风味食品杏仁奶水果小吃椰子

桃子八角苹果果味鲜果调味桃子

数码单反奥林巴斯-d e-m5标志ii奥林巴斯

雪靴奥胡斯鞋洛拉拉蒙纳店-汤米希尔菲格

Karine&Jeff旗舰店-460克沙特尼蔬菜之旅-500克-扁豆汤

福克斯猎犬大学德州大学奥斯汀服装销售业务-SUM

奥斯汀佩伊州立大学标志品牌产品设计-体育呼啦圈

朱尔斯・马斯特里赫特学生奥托利亚学校马塞尔・明尔斯组织大学-学生

高级lvmh服装配件-威登太阳镜

蜘蛛-女人(格温・斯泰西)

奥斯汀标志设计卢米娜剪贴画-教皇

印第安纳波利斯艺术中心推广印第安纳公司。组织-非营利组织

奥格里斯摄影剪贴画-木瓜

夏天冰冻饮料奥利奥奶茶

夏日甜品奥利奥奶茶

柚子水果食果皮柚子

美味冰淇淋

iPhone x Apple JD.com富士奥格利斯-红色简单苹果装饰图案

奥丁・阿斯加德・斯莱普尼尔挪威神话

影迷艺术堕落艺术奥斯传奇生物-雷神

番茄汁樱桃番茄炒鸡蛋蔬菜半番茄

安格斯牛红安格斯牛小牛手术剪贴画

番茄汁蔬菜水果-番茄